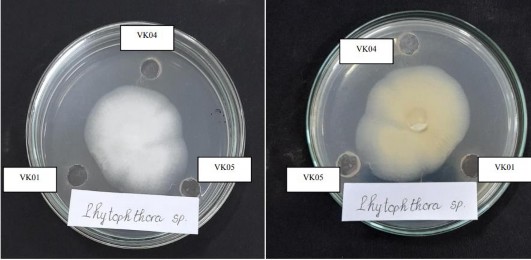
Hình 15 Hoạt tính kháng Phytophthora của các hợp chất VK01 VK04 và VK05 sau 3 ngày 1
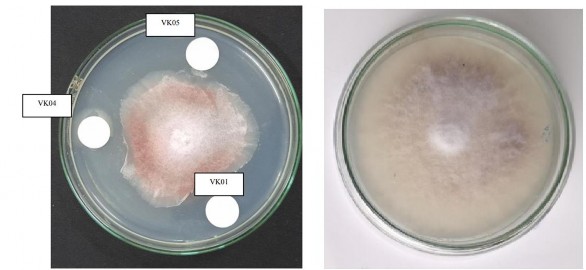
Hình 16 Hoạt tính kháng nấm Fusarium của các hợp chất VK01 VK04 và VK05 sau 7 2
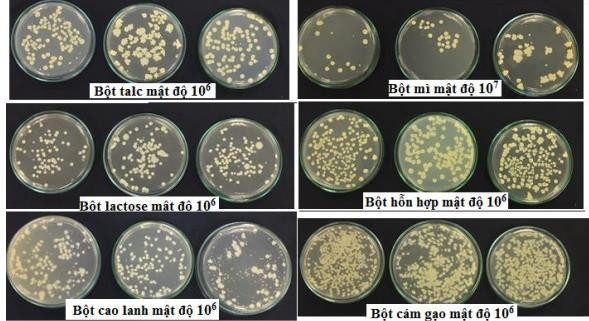
Hình 23 Mật độ vi khuẩn Bacillus velezensis ĐS29 trong chế phẩm với các chất 10

Hình 15. Hoạt tính kháng Phytophthora của các hợp chất VK01, VK04 và VK05 sau 3 ngày ở nồng độ 20mg/ml
Hình 16. Hoạt tính kháng nấm Fusarium của các hợp chất VK01, VK04 và VK05 sau 7 ngày ở nồng độ 20mg/ml

Hình 17. Sợi Phytophthora bị gãy gập, xoắn ở phần tiếp giáp với đĩa giấy chứa hợp chất tinh khiết

Hình 18. Sợi Phytophthora bị xoắn ở phần tiếp giáp với đĩa giấy chứa hợp chất tinh khiết

Hình 19. Nấm Phtophthora và hệ sợi ở đĩa đối chứng

Hình 20. Hệ sợi nấm Fusarium bị đứt gãy

Hình 21. Trứng tuyến trùng bị tác động bởi hợp chất tinh khiết
|
Có thể bạn quan tâm!
-
Xác Định Thành Phần Hóa Học Trong Dịch Nuôi Cấy Của Chủngvi Khuẩn Vùng Rễ Tuyển Chọn Có Khả Năng Kháng Nấm Fusarium Bằng Phân Tích Lc-Ms Và Gc-Ms -
Tuyển chọn, nghiên cứu đặc tính kháng tác nhân gây bệnh và tạo chế phẩm phòng trừ bệnh rễ của các chủng vi khuẩn vùng rễ cây hồ tiêu Piper nigrum L. tại Tây Nguyên - 26 -
Tuyển chọn, nghiên cứu đặc tính kháng tác nhân gây bệnh và tạo chế phẩm phòng trừ bệnh rễ của các chủng vi khuẩn vùng rễ cây hồ tiêu Piper nigrum L. tại Tây Nguyên - 27
Xem toàn bộ 224 trang tài liệu này.
Hình 22. Hệ thống lên men vi khuẩn DS29 lúc 8g
Hình 23. Mật độ vi khuẩn Bacillus velezensis ĐS29 trong chế phẩm với các chất mang khác nhau ở thời điểm bảo quản 90 ngày
| |
| |
|
|

Hình 24. Các chất mang sau khi phối trộn với dịch vi khuẩn

Hình 25. Mật độ vi khuẩn trong chế phẩm vi khuẩn vùng rễ RB.CJ41

Hình 26. Hoạt tính kháng nấm của chế phẩm chứa vi khuẩn RB.CJ41









